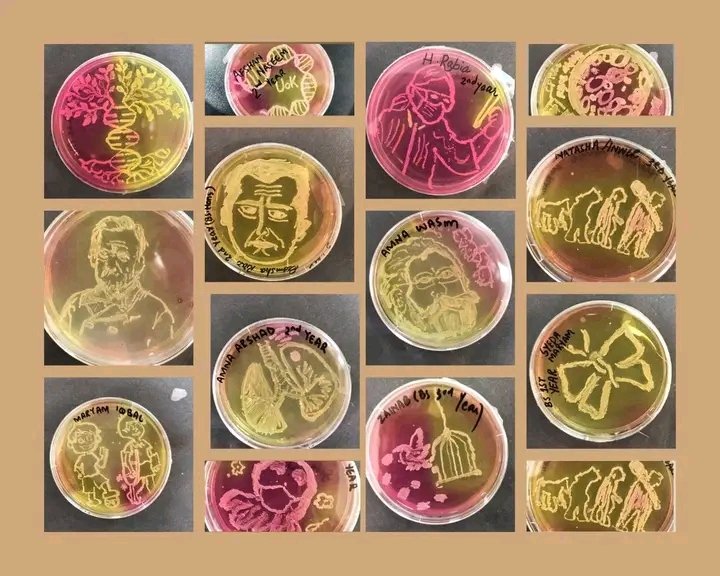
🎉 Celebrating a year of creativity, growth, and beautiful agar art achievements! 🌟 Grateful for this journey, and doubly so, as it's my birthday too! 🎂 Here's to another year of inspiration and artistry! 🥳🥂 

#OneYearOfAgarArt #BirthdayCheers

Mahreen Wali
@mahreenwali
Research Officer | Microbiologist | Molecular Biologist
ID: 1160854448773705728
12-08-2019 10:04:03
217 Tweet
21 Takipçi
96 Takip Edilen


Each day KE is making difficult for us to live. What do you want KE? Why are you making out lives miserable? #stoploadshedding Government of Pakistan Sindh Chief Minister House Government of Sindh


Attending #TrialSampleTwitter? Join "Sci-Forge Hub Community " at 10/25/2023 01:45 PM through the Whova event app. Mahreen Wali